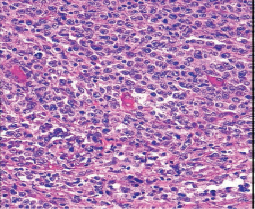

Accurate anatomical pathology and biological diagnosis is essential for the proper treatment of cancer patients.
Morphology, the gold standard for any initial analysis—cytological analysis using a microscope to examine cells and histological analysis to examine tissues—is now complemented by a multidisciplinary approach: biological and genetic analysis according to WHO criteria. These costly techniques are not yet fully accessible to low- and middle-income countries, exacerbating inequalities in access to healthcare in these countries.
Several approaches are being implemented within the GCCA to improve diagnostic procedures within these countries, particularly in Africa.
Improvements in standard cytology and pathological anatomy techniques and access to telopathology.
The latter is currently carried out by transmitting digitized microscopic images of interest (JPEG images) via the internet. These images are selected by local cytologists or anatomic pathologists using a microscope with a digital camera connected to a computer and a scientific exchange platform, the "i-Path" platform linked to the INCTR (International Network for Cancer Treatment and Research). This platform comprises several scientific exchange groups made up of identified doctors (hematologists, anatomic pathologists, clinicians) linked to a group of international experts in various fields of cancer. The latter comment on the images, helping local practitioners to make a diagnosis.
This is an already operational network involving several centers in the following countries:
Senegal, Ivory Coast, Democratic Republic of Congo, Cameroon, Benin, Madagascar, Burkina Faso, Mali, Morocco, Tunisia.

The implementation of techniques to characterizecells:
- Immunohistochemistry on sections.
- Flow cytometry.
- Chromosome analysis.




The implementation of complementary techniques necessary for diagnosis is carried out in coordination with cancer treatment projects.
Martine RAPHAËL - Aurore COULOMB - Elisabeth AUBERGER